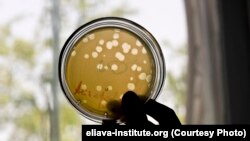
გ. ელიავას სახელობის ბაქტერიოფაგიის, მიკრობიოლოგიისა და ვირუსოლოგიის ინსტიტუტი

რა უნდა ქნას კაცმა, როცა ანტიბიოტიკი აღარ მოქმედებს? ასეთი პრობლემის მქონე ადამიანებმა საქართველოსკენ გასწიეს, რათა იქ ბაქტერიოფაგებით იმკურნალონ. ამასობაში ფაგები ბელგიაშიც დაუშვეს, წერს თავის სტატიაში „დოიჩე ველე“.
„დოიჩე ველე“ ნიდერლანდელი, მაასტრიხტელი ქალის, ტანია დიდერენის, მაგალითზე გვიამბობს, როგორ ჩავიდა გამოუვალ მდგომარეობაში მყოფი კანის ქრონიკული დაავადებით - თმის ფესვის მტკივნეული ანთებით - შეწუხებული პაციენტი საქართველოში. სამშობლოში დიდერენს სულ უფრო ძლიერ ანტიბიოტიკებს უნიშნავდნენ და მედიკამენტების ეს ჯგუფი მასზე აღარ მოქმედებდა. წელს, აგვისტოში, 50 წლის ქალმა გადაწყვიტა, ორი კვირით წასულიყო საქართველოში და მკურნალობა ბაქტერიოფაგის საშუალებით გაეგრძელებინა.
მკურნალობის ეს ფორმა დასავლეთში მიღებული არ არის. დიდერენს მოუწია თითქმის ოთხი ათასი ევროს გაღება მკურნალობისთვის იმ იმედით, რომ ეშველებოდა. „დოიჩე ველე“ მკითხველს განუმარტავს, რომ ბაქტერიოფაგები ვირუსებია, რომლებიც პაციენტის ორგანიზმში „მასპინძელ ბაქტერიაზე“ სახლდებიან, რათა იარსებონ. ბაქტერიის უჯრედში ფაგები მრავლდებიან, ჩნდება ახალი ფაგები, ისინი კი სხვა ბაქტერიების უჯრედში სახლდებიან, სანამ ყველა ბაქტერია არ დაიღუპება.
ფაგის უპირატესობა ისაა, რომ ის, ანტიბიოტიკისგან განსხვავებით, მიზნობრივად ერევა ბაქტერიას და არ კლავს „კარგ“ ბაქტერიებს, რადგან ის კონკრეტული ბაქტერიის წინააღმდეგ არის მიმართული...
ტანია დიდერენის თქმით, ფაგებს რაღაც სოკოს მსგავსი გემო აქვთ. როცა საქართველოში მიდიოდა, ნერვიულობდა, ღელავდა და, პირველ რიგში, ბრაზით იყო აღსავსე ჰოლანდიელი ექიმების მიმართ, რომლებიც ვერ დაეხმარნენ.
ფაგების შესახებ მან ტელევიზიით შეიტყო და გაეშურა კიდეც საქართველოსკენ, სადაც, სტატიის ავტორების თანახმად, გიორგი ელიავას სახელობის ინსტიტუტში უკვე 1923 წლიდან იკვლევენ ფაგებს და ეს ქვეყანა მსოფლიოს ცენტრი გახდა ფაგებით მკურნალობის სფეროში. „დოიჩე ველეს“ სტატიის ავტორი წერს, რომ ცივი ომის პერიოდში საბჭოთა კავშირში ძნელად ხელმისაწვდომი იყო ანტიბიოტიკები და ამიტომ ფაგებით მკურნალობა საუკეთესო საშუალება იყო ინფექციური დაავადებების დროს. გამოცემისთვის ცნობილია, რომ ელიავას ინსტიტუტს თბილისში ბაქტერიოფაგების უდიდესი კოლექცია აქვს მსოფლიოში.
დიდერენმა თბილისში მკურნალობის ორკვირიანი კურსი გაიარა და შემდეგ ფაგებით სავსე დიდი ჩანთით დაბრუნდა ჰოლანდიაში. ახლა ის თავს უკეთ გრძნობს, მეტი ენერგია აქვს და პატარა ანთებებმა სხეულზე გაუარა. დიდი ანთებები კვლავ აქვს ხოლმე, მაგრამ იშვიათად და არა ისე მწვავედ, როგორც ადრე.
ყოველ სამ თვეში ერთხელ დიდერენი ბელგიაში მიემგზავრება, მისი სახლიდან არცთუ ისე შორს, რათა საქართველოდან მიღებული 500 ევროს ღირებულების ბაქტერიოფაგების ახალი პარტია წამოიღოს. დაზღვევა ფაგებს არ ფარავს. ბელგია ერთადერთი დასავლეთევროპული ქვეყნაა, სადაც ფაგები დაშვებულია. სხვა ქვევნებში მათ მხოლოდ იშვიათად იყენებენ ადამიანების სიცოცხლის გადასარჩენად ან ძლიერ ტკივილების გასაყუჩებლად. ტანია დიდერენი დარწმუნებულია, რომ ფაგები ბევრ ადამიანს დაეხმარებოდა ევროპაში.
„დოიჩე ველე“ წერს, რომ გერმანიასა და ნიდერლანდში ახლა მიმდინარეობს საპილოტე კვლევა, შესაძლებელია თუ არა პაციენტებისთვის ბაქტერიოფაგების გამოწერა...
ფაგის უპირატესობა ისაა, რომ ის, ანტიბიოტიკისგან განსხვავებით, მიზნობრივად ერევა ბაქტერიას და არ კლავს „კარგ“ ბაქტერიებს, რადგან ის კონკრეტული ბაქტერიის წინააღმდეგ არის მიმართული. თუმცა ფაგების მიმართაც შეიძლება ბაქტერიას გაუჩნდეს მედეგობა. ფაგებს ინდივიდუალურად ამზადებენ კონკრეტული პაციენტებისთვის, უპირატესად, საქართველოში.
ფაგები, „დოიჩე ველეს“ ინფორმაციით, ბელგიაში დაშვებულია. დასავლეთ ევროპის ქვეყნებში ასე, ინდივიდუალურად, თითოეული პაციენტისთვის წამლის დამზადების მეთოდი ვერ თავსდება წამლების წარმოების დადგენილ ნორმებში. ბელგიაში ჯანმრთელობის დაცვის კვლევითი ინსტიტუტი ახერხებს თანამშრომლობას ექიმთან, პაციენტთან, მწარმოებელთან, ფარმაცევტსა და წამლების უწყებასთან ერთად და გასცემს საგანგებო სერტიფიკატს ამა თუ იმ ფაგისთვის. აფთიაქებს შემდგომ შეუძლიათ, გარკვეული წესების დაცვით წამალი აწარმოონ.
დედოფალ ასტრიდის სახელობის სამხედრო საავადმყოფოში მუშაობს დოქტორი ჟან-პოლ პირნი, რომელიც ფაგებს იკვლევს. ამ საავადმყოფოში 30-მდე ადამიანს მკურნალობდნენ წელს. მკვლევრის აზრით, საჭიროა ფარმაცევტული საწარმო, რომელიც დაამზადებდა ფაგებს, რადგან საავადმყოფოში ეს შეუძლებელია. მისი აზრით, ფაგები ვერ შეცვლის, არამედ მხოლოდ განავრცობს ანტიბიოტიკებს, რათა ისინი ერთად იქნეს გამოყენებული მეტი ეფექტისთვის.
ტანია დიდერენი ამბობს, რომ საქართველოში სამკურნალოდ მგზავრობა რთულია. ეს ქვეყანა შორსაა, ძვირია გზა, მაგრამ ის იმედოვნებს, რომ ევროპის სხვა ქვეყნებშიც შესაძლებელი გახდება ფაგების წარმოება.
მისი და სხვა, მსგავსი პრობლემების მქონე, პაციენტების დასამშვიდებლად „დოიჩე ველე“ წერს, რომ გერმანიასა და ნიდერლანდში ახლა მიმდინარეობს საპილოტე კვლევა, შესაძლებელია თუ არა პაციენტებისთვის ბაქტერიოფაგების გამოწერა. საფრანგეთმა უკვე შეიტანა ქვეყანაში ფაგები ბელგიიდან და დათანხმდა მათ გამოყენებას.